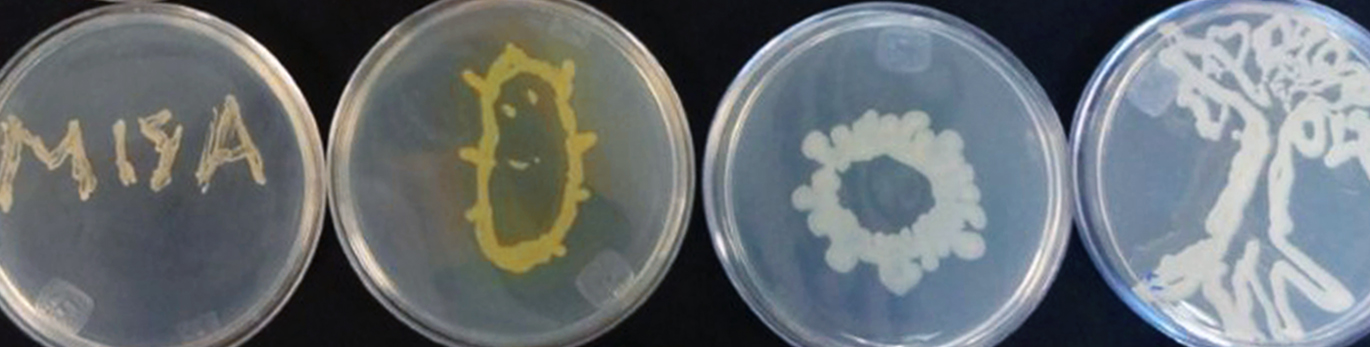

El efecto peninsular: Baja California y sus gradientes de diversidad aviar
Marisol Martínez Vadillo, Claudio Mota Vargas y Octavio Rojas Soto
Red de Biología Evolutiva

En la Península de Baja California se presenta un fenómeno conocido como efecto peninsular, el cual consiste en poseer un mayor número de especies en la base; es decir, en su extremo más próximo al continente, y menos especies en la punta; es decir, en su extremo más distal. Este efecto peninsular, en combinación con sus diferentes climas genera gradientes de diversidad biológica que, en el caso de las aves, es muy evidente y de gran importancia para su conservación.